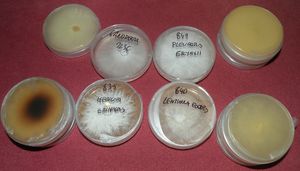
Klikni pro velký obrázek

| |< < > >| | ||
| * 2010-12-28 21:50:36 | houbomil |  Ahoj Lidičky-poněvadž nebudu do 3ledna u počítače tak Vám všem přeji k novému roku hodně štěstí,zdraví a mnoho krásných zážitků při houbaření po celý příští rok Ahoj Lidičky-poněvadž nebudu do 3ledna u počítače tak Vám všem přeji k novému roku hodně štěstí,zdraví a mnoho krásných zážitků při houbaření po celý příští rok Přidám několik fotek složených z letošních hub,které jsem poslal přátelům a rodině a prostřednictvím Houbaření také Vám  Tak se mějte hezky. Tak se mějte hezky. |
| + 2010-12-28 21:52:09 | houbomil |  2. 2. |
| - 2010-12-28 21:53:15 | houbomil |  3. 3. |
| * 2010-12-28 21:54:54 | houbomil |  4. 4. |
| + 2010-12-28 21:55:53 | houbomil |  5. 5. |
| - 2010-12-28 21:56:59 | houbomil |  6. 6. |
| * 2010-12-28 21:58:14 | houbomil |  7. 7. |
| * 2010-12-28 21:59:06 | houbomil |  8. 8. |
| * 2010-12-28 22:00:58 | houbomil |  A to by mohlo stačit tak se mějte A to by mohlo stačit tak se mějte |
| * 2010-12-28 22:40:52 | kápo | kéž by to nemuselo stačit   děkujem a tobě taky děkujem a tobě taky |
| * 2010-12-29 05:57:02 | fina | děkujeme a necht se ti daří v tom Novém roce tak jako letos        |
| * 2010-12-29 06:02:57 | Mahony | Nádherně zpracované  |
| * 2010-12-29 08:01:43 | Kraken | Jiří, krása! To by byl parádní kalendář. To by byl parádní kalendář. |
| * 2010-12-29 13:10:44 | Rikki | Máš to moc hezký!!!...a jak už tu kdosi psal,byl by z toho nádherný kalendář. Stejně jsem zjistil,že se raději podívám na fotografie,něž abych to hledal v počítači  |
| * 2010-12-29 13:13:46 | Rikki | Krakene promiň nemohl jsem si vzpomenout při psaní,na tvou přezdívku |
| * 2010-12-29 16:18:13 | javas | Pěkně jsi si Jiříku vyhrál   |
| + 2010-12-28 21:52:59 | Forrest Run | Díky, díky, díky, Draku, Tobě taky takovou porci!:o) Pozdravuj Křepelinku v Horách Železných-a pořádně hluboko! A ja na Nový Rok, tak po celý rok, Ty Bejku:o) Pozdravuj Křepelinku v Horách Železných-a pořádně hluboko! A ja na Nový Rok, tak po celý rok, Ty Bejku:o)    |
| - 2010-12-28 22:58:16 | marek.11 | ta sestavička je parádní   ,moc dík a vše nej do Nového roku ,moc dík a vše nej do Nového roku |
| * 2010-12-29 09:25:26 | zdeno | Moc pěkné,kvalitní...  |
| + 2010-12-29 11:37:30 | fáfa | Moc pěkná prácička   |
| + 2010-12-29 16:12:54 | Richard z Beskyd | Taky se měj |
| - 2010-12-29 16:34:43 | MILANOSS | Ale,toto je moc pěkná roční kolekce    A ti též přeji hodně štěstí v Novém roce A ti též přeji hodně štěstí v Novém roce  |
| * 2010-12-28 20:25:48 | zdeno |  Forrestovi detailistovi... Forrestovi detailistovi... |
| + 2010-12-28 20:26:47 | zdeno |  ...vločkové drobnosti... ...vločkové drobnosti... |
| - 2010-12-28 20:28:07 | zdeno |  No a když už jsem "on the road"... No a když už jsem "on the road"... |
| * 2010-12-28 20:29:08 | zdeno |  ..dvé omrzlých olší... ..dvé omrzlých olší... |
| + 2010-12-29 08:02:41 | Kraken | Ovšem tohle je super makro! |
| + 2010-12-28 21:55:51 | Forrest Run | Děkuju moc za sebe i za Kačkodlačku, Ty ÓbrVločky jsou opravdu uchacující!  Taky se mi vélmi líbí ta druhá zvětšenina VolšoŠišek! Taky se mi vélmi líbí ta druhá zvětšenina VolšoŠišek!     A mám Ti vyřídit, že ten Přátelskej Dráček "Olšodlak" na první olšofotce je prostě COOL!     |
| + 2010-12-29 16:13:38 | Richard z Beskyd |  |
| - 2010-12-29 20:29:43 | MILANOSS | Opět paráda ledofotiči    |
| * 2010-12-28 17:17:17 | Forrest Run |  Forrestova pěstírna! Forrestova pěstírna! Konečně mi to 4.prosince začalo fruktifikovat!      |
| + 2010-12-28 17:20:00 | Forrest Run |  Největší problém je udržet to v panelákovým vzduchu, kterej má se svejma 30-40 procentama r.v. nechutně blízko k Sahaře Největší problém je udržet to v panelákovým vzduchu, kterej má se svejma 30-40 procentama r.v. nechutně blízko k Sahaře ....i jsem si kvůlivá tomu kupovalů druhej vlhkoměr, protože jsem si myslel, že ten první je nějakej chorej nebo šílenej! ....i jsem si kvůlivá tomu kupovalů druhej vlhkoměr, protože jsem si myslel, že ten první je nějakej chorej nebo šílenej!    |
| + 2010-12-28 17:23:00 | Forrest Run |  Ale zas jí nemůže bejt moc, aby to nechytlo bakteriózu nebo aby člověk nezadusil mycelium, suboptimální vlhkost vzduchu působí negativně jak na nasazování primordií, tak na následnou kvalitu a skladovatelnost výpěstků, ale to Vám nikdo, pokud to nejsou "provařený" žampióny, jaksi neřekne! Ale zas jí nemůže bejt moc, aby to nechytlo bakteriózu nebo aby člověk nezadusil mycelium, suboptimální vlhkost vzduchu působí negativně jak na nasazování primordií, tak na následnou kvalitu a skladovatelnost výpěstků, ale to Vám nikdo, pokud to nejsou "provařený" žampióny, jaksi neřekne! |
| + 2010-12-28 17:29:09 | Forrest Run |  Stejně tak Vám nikdo neřekne, že třeba Šii-take vypouští nějaký poměrně silný inhibitory fruktifikace ostatních houbelec, takže jsem s vráskama na čele pozoroval, jak Houževnatec(na snímku) roste a košatí, zatímco Hlíva máčková(uprostřed skupinovejch snímků) a Šupinofka Nameko(na dalším snímku vlevo) vysloveně chřadne! Stejně tak Vám nikdo neřekne, že třeba Šii-take vypouští nějaký poměrně silný inhibitory fruktifikace ostatních houbelec, takže jsem s vráskama na čele pozoroval, jak Houževnatec(na snímku) roste a košatí, zatímco Hlíva máčková(uprostřed skupinovejch snímků) a Šupinofka Nameko(na dalším snímku vlevo) vysloveně chřadne! Až když jsem Šii-take o pár dní pozdějc sklidil, tak se zbejvající houbelec "rozvášnily" a dohnaly zpoždění! Až když jsem Šii-take o pár dní pozdějc sklidil, tak se zbejvající houbelec "rozvášnily" a dohnaly zpoždění!    |
| + 2010-12-28 17:32:49 | Forrest Run |  A taky nikde nevyčtete, že pokud Vám šupinofka nebo i jiný houbelec udělaj takový jakoby paličky na bubny(tlustší hnátička než klóbrc), je to vinou příliš vysoký koncentrace CO2 při nasazování primordií....když tomu zase ale vyvětráte moc, tak to buď "nastydne", jako se mi to "podařilo" s Hlívou máčkovou nebo je tam i riziko kontaminace sporama plísní! A taky nikde nevyčtete, že pokud Vám šupinofka nebo i jiný houbelec udělaj takový jakoby paličky na bubny(tlustší hnátička než klóbrc), je to vinou příliš vysoký koncentrace CO2 při nasazování primordií....když tomu zase ale vyvětráte moc, tak to buď "nastydne", jako se mi to "podařilo" s Hlívou máčkovou nebo je tam i riziko kontaminace sporama plísní!    |
| + 2010-12-28 17:35:24 | Forrest Run |  Ještě aspoň jedna fotka bez blesku, fotit něco v akvárku je docela výzva Ještě aspoň jedna fotka bez blesku, fotit něco v akvárku je docela výzva ....když si odkryju vrchní sklo, tak se mi zase za pár fteřin zamlží objektif u foťáku! ....když si odkryju vrchní sklo, tak se mi zase za pár fteřin zamlží objektif u foťáku!   |
| + 2010-12-28 17:38:32 | Forrest Run |  A tady ještě důkaz neskutečný vitality šii-take....tyhle pidi houbičky za 24 hodin "odstrkaj" celej ten cca 3kg těžkej plok ke druhý stěně akvárka! A tady ještě důkaz neskutečný vitality šii-take....tyhle pidi houbičky za 24 hodin "odstrkaj" celej ten cca 3kg těžkej plok ke druhý stěně akvárka!    Pokračování příště!:o) Pokračování příště!:o)   Jó, Kudlo, Ježura Ti u nás nechal právě takovej utěšeně prorůstající substrátek!     |
| - 2010-12-28 19:25:30 | Kudláček | Peťane odkud bereš sadbu? Je to od Jirky Václavíka? Ježura, že by zabloudil, nevěřím   Jen pro zajímavost Ti posílám k nakouknutí, jak by se měl jakýkoliv druh houby skladovat apod. Např: Označení houby - Žampion zahradní. Omezení v použití houby. Houby volně rostoucí lze používat pouze pro průmyslové zpracování. Použitelnost čerstvých hub. Houby volně rostoucí - 3 dny ode dne sběru, houby pěstované - 5 dní ode dne sběru. Skladování čerstvých hub - 0 - 10 °C u volně rostoucích, 0 - 6 °C u hub pěstovaných. Skladování sušených hub - do 20 °C a relativní vlhkosti nejvýše 65% Označení houby - Liška obecná. Omezení v použití houby - Není. Použitelnost čerstvých hub - 3 dny ode dne sběru. Skladování čerstvých hub - 0 - 10 °C. Skladování sušených hub - do 20 °C a relativní vlhkosti nejvýše 65% Označení houby - Hřib borový. Omezení v použití houby- V ČR lze obchodovat pouze s houbami z dovozu. Použitelnost čerstvých hub - 3 dny ode dne sběru. Skladování čerstvých hub 0 - 10 °C. Skladování sušených hub do - 20 °C a relativní vlhkosti nejvýše 65% |
| * 2010-12-28 19:50:04 | Forrest Run | To znám, dokonce to byla jedna ze zkouškovejch otázek, ale i tak děkuju za osvěžení!      |
| - 2010-12-29 15:35:50 | fáfa |  Forre mě to doma roste z březovího klacku Forre mě to doma roste z březovího klacku |
| * 2010-12-29 16:25:17 | kápo | tož súdruhovia ak máte viacej fotografií a najme poznatkov o šiitake,bolo by naozaj skvelé,keby ste sa pokusili ho umiestniť do tunajšího atlasa hej ďakujem pekne,no terazky som stále iba kápom ďakujem pekne,no terazky som stále iba kápom    |
| + 2010-12-28 17:41:24 | Forrest Run |  A na závěr jsem si ještě dovolil se na odlehčení přihodit pár snímků tropickejch hříbků, aneb jak se houbaří v Austrálii, Novým Zélandu a v teplejších částech USA.....do lesa s kárkou nebo s rudlikem!?! A na závěr jsem si ještě dovolil se na odlehčení přihodit pár snímků tropickejch hříbků, aneb jak se houbaří v Austrálii, Novým Zélandu a v teplejších částech USA.....do lesa s kárkou nebo s rudlikem!?!     |
| - 2010-12-28 17:42:52 | Forrest Run | Phlebopus(Boletus) marginatus... |
| + 2010-12-28 17:43:22 | Forrest Run |   |
| + 2010-12-28 17:43:50 | Forrest Run |   |
| + 2010-12-28 17:46:18 | Forrest Run |  Tohle je hardcore Tohle je hardcore , Boletus(Phlebopus)colossus, tem může mít průměr klóbrcu až 1m, vážit okolo 30kg a je jedlej , Boletus(Phlebopus)colossus, tem může mít průměr klóbrcu až 1m, vážit okolo 30kg a je jedlej ....měl by bejt mykorhizní s blahovičníkama! ....měl by bejt mykorhizní s blahovičníkama!     |
| + 2010-12-28 17:46:48 | Forrest Run |   |
| + 2010-12-28 17:49:05 | Forrest Run |  A to je pro dnešek opravdu fšecko!:o) A to je pro dnešek opravdu fšecko!:o) Zejtra se těšte na ještě větší(jedlý) houbelec....Termitovníky!:o) Zejtra se těšte na ještě větší(jedlý) houbelec....Termitovníky!:o)     |
| - 2010-12-28 18:50:37 | marek.11 | hezkou mikofarmičku sis udělal v paneláku |
| * 2010-12-28 18:51:23 | marek.11 |    |
| - 2010-12-28 19:27:35 | Kudláček | Sqvělé megovky muhehe  |
| * 2010-12-28 19:59:48 | Forrest Run |  Něco mám z ofiko distribuční sítě, něco ze zahraničí, něco už jsem si i vyprodukoval sám Něco mám z ofiko distribuční sítě, něco ze zahraničí, něco už jsem si i vyprodukoval sám a hlavně mám užitečný kontakty na různý univerzity f Čechách i na Moravě!... a hlavně mám užitečný kontakty na různý univerzity f Čechách i na Moravě!...   .Už toho mám v ledničce na několik trestů smrti! .Už toho mám v ledničce na několik trestů smrti!  Nicméně nechci ty moje vysokoškolský dobrodince nikterak diskreditovat, takže podrobnosti raději přes mail nebo ještě líp-osobně, Drakouši! Nicméně nechci ty moje vysokoškolský dobrodince nikterak diskreditovat, takže podrobnosti raději přes mail nebo ještě líp-osobně, Drakouši! Tohle pěstování na agaru a převočkovávání z něj už je docela pakárna, musíš si dávát strašlivýho majzla na kontaminaci jak při vaření agaru a aditif, tak při inokulaci i během jakýhokolif otvírání Petriho misek, zrovna fčera jsem převočkovával "na zrno" a ruce jsem si během hodiny myl víc jak 50X, takhle čistotnej jsem nebyl ani když jsem si, v minulým tisíciletí Tohle pěstování na agaru a převočkovávání z něj už je docela pakárna, musíš si dávát strašlivýho majzla na kontaminaci jak při vaření agaru a aditif, tak při inokulaci i během jakýhokolif otvírání Petriho misek, zrovna fčera jsem převočkovával "na zrno" a ruce jsem si během hodiny myl víc jak 50X, takhle čistotnej jsem nebyl ani když jsem si, v minulým tisíciletí , coby Švarný Jinoh hrával s holkama na pana doktora! , coby Švarný Jinoh hrával s holkama na pana doktora!     |
| + 2010-12-28 20:02:07 | Forrest Run | Chobotničky Chobotničky .....za pár let prej poznám jen podle pohledu na nepopsanou Petriho misku jak rod a druh, tak i potenciál toho kterýho produkčního kmene! .....za pár let prej poznám jen podle pohledu na nepopsanou Petriho misku jak rod a druh, tak i potenciál toho kterýho produkčního kmene!     |
| + 2010-12-28 20:15:13 | Kudláček | V tomto mě hodně zasvětil a vysvětlil Pája Havránek. Taky jsem mu udělal několik různých druhů otisků ... Jen tak dál. |
| - 2010-12-28 21:49:53 | Forrest Run |  Fšechno vím, i o tom Kotrči Němcovým! Fšechno vím, i o tom Kotrči Němcovým! Tak se ho schválně zeptej, kolik jsem mu letos udělal sporootisků kačenek, smržů, májovek, kotrčů, ucháčů,....určitě přes 100! Tak se ho schválně zeptej, kolik jsem mu letos udělal sporootisků kačenek, smržů, májovek, kotrčů, ucháčů,....určitě přes 100!      To jeho nadšení pro věc je tak nakažlivý!  Na to, jak je to starej pán, je neskutečně agilní a svěží mysli a i když má titulů před i za jménem hafo, je neskutečně skromnej a ochotně mi do zblbnutí vysvětluje i ty nejzákladnější věci, tak abych to i já pobral!    |
| - 2010-12-28 20:10:25 | Forrest Run | Na spřátelených stránkách k týhle fotce Tonda.Houba, alias Judr.Aleš Vít poznamenal:"Ta roztomilá dívenka, dnes bezpochyby už obletovaná slečna, se jmenuje Caro. S ní a zejména s jejími rodiči jsme s manželkou strávili báječný den, nejen při houbaření v severní části Sydney..." Svět je malej, to říkám pořád!:o) |
| * 2010-12-29 12:44:26 | Rikki | Teda Peťane ...ty ses rozjel ...ty ses rozjel !!!Ale to je dobře,protože se zase mohu něco přiučit.Sám jsem zkoušel pěstovat opeňky na dubovém pařezu naočkováním,ale nebylo z toho nic !!!Ale to je dobře,protože se zase mohu něco přiučit.Sám jsem zkoušel pěstovat opeňky na dubovém pařezu naočkováním,ale nebylo z toho nic ...ale při pohledu na tvé výsledky to člověka potěší a ty úspěchy ti ze srdce přeju!! ...ale při pohledu na tvé výsledky to člověka potěší a ty úspěchy ti ze srdce přeju!!No a ty fotky těch zahraničních hřibů,to se ani nechce věřit...  |
| + 2010-12-29 08:05:33 | Kraken | Gratulace k fruktifikaci! |
| * 2010-12-28 10:44:03 | Rikki |  Tak mi to nadá, abych se nepodělil o dárek k vánocům... Tak mi to nadá, abych se nepodělil o dárek k vánocům... |
| + 2010-12-28 10:45:09 | Rikki |  ...dostal jsem fotoknihu letošních nejhezčích nálezů... ...dostal jsem fotoknihu letošních nejhezčích nálezů... |
| + 2010-12-28 10:46:16 | Rikki |  ...alespoň budou mít děti na mne památku ...alespoň budou mít děti na mne památku |
| + 2010-12-28 10:48:05 | Rikki |  ...škoda,že to není tak ostré,jako doopravdy... ...škoda,že to není tak ostré,jako doopravdy... |
| + 2010-12-28 10:49:17 | Rikki |  ...je to bez popisu schválně,abych mohl zkoušet vnoučata ...je to bez popisu schválně,abych mohl zkoušet vnoučata |
| - 2010-12-28 13:33:29 | Kudláček | Václave moc dobrý. To sám, nebo překvapení ... |
| * 2010-12-28 14:51:47 | Rikki | Sám jsem vybíral a překvapení bylo,jak to dopadne |
| - 2010-12-28 21:29:57 | houbomil | Hezký-taky jsem myslel na kalendář ale nedostal jsem se k tomu   |
| - 2010-12-29 08:03:50 | Kraken | Rikky, to se ti povedlo! |
| - 2010-12-29 16:20:53 | javas | Václave, klobouk dolů   |
| + 2010-12-28 10:51:22 | Rikki | Kniha má 50 listů,ale všechny sem dávat nebudu ,to byste mě hnali ,to byste mě hnali ...Tak všem pohodu a krásné chvíle... ...Tak všem pohodu a krásné chvíle... |
| - 2010-12-28 11:53:36 | kápo | very good idea  :P :P : : |
| * 2010-12-28 16:20:49 | Prosty | To je fakt dobrý  |
| + 2010-12-28 17:15:23 | Forrest Run | Vypadá to víc jak dobře, Vendelínku!     "Rikky sobě!"  |
| - 2010-12-28 18:46:53 | marek.11 | pěkné |
| * 2010-12-29 09:23:46 | zdeno | Moc pěkné...   |
| + 2010-12-29 20:31:20 | MILANOSS | To nemá chybu , gratulace    |
| * 2010-12-28 08:35:44 | fina |  je tu i v zimě pěkně a čistý vzduch než v té kotlině je tu i v zimě pěkně a čistý vzduch než v té kotlině |
| * 2010-12-28 08:32:01 | fina |  okolí Sněžníku 27.12.2010 okolí Sněžníku 27.12.2010 |
| + 2010-12-28 08:32:45 | fina |    |
| - 2010-12-28 13:34:14 | Kudláček | Lolo, to se běžkuje, žue?! |
| * 2010-12-29 05:59:21 | fina | dnes tu mrzlo tak nevím zda ještě jít na ty běžky   |
| + 2010-12-28 09:17:35 | kápo | ve zdravém těle zdravý duch-a ty jsi ho dokonce vyfotila    |
| - 2010-12-28 18:45:48 | marek.11 | hezké jak z pohádky |
| + 2010-12-28 19:13:05 | Forrest Run |   |
| + 2010-12-28 20:34:00 | zdeno | Hezky jsi to nafotila...  |
| - 2010-12-29 20:33:07 | MILANOSS | Pěkně ti vyšlo počasí    Já takové štěstí neněl . Hezké fotky Já takové štěstí neněl . Hezké fotky       |
| * 2010-12-27 20:30:42 | zdeno |  Nejen vlekaři mají dobré časy... Nejen vlekaři mají dobré časy... |
| + 2010-12-27 20:31:22 | zdeno |  Kam koukneš,něco pěkného... Kam koukneš,něco pěkného... |
| - 2010-12-27 20:32:21 | zdeno |  ...příroda testuje svou odolnost.. ...příroda testuje svou odolnost.. |
| * 2010-12-27 20:33:03 | zdeno |  ...ale žádné strachy... ...ale žádné strachy... |
| + 2010-12-27 20:34:03 | zdeno |  ...to všechno tady už za ty miliony let bylo... ...to všechno tady už za ty miliony let bylo... |
| - 2010-12-27 21:18:11 | Kudláček | Ty vločky jsou doopravdy super   |
| - 2010-12-27 21:44:23 | houbomil |   |
| - 2010-12-28 14:54:13 | Rikki | Pripadá mi,jako bys byl na školení u dědy mrazíka ...ale jinak to nemá chybu ...ale jinak to nemá chybu |
| + 2010-12-27 20:57:44 | Forrest Run | Zede sqělý! Neudělal bys ještě detail těch neporušenejch vloček z 10.hodiny, please? Neudělal bys ještě detail těch neporušenejch vloček z 10.hodiny, please? |
| - 2010-12-28 14:03:38 | zdeno | Ze které fotky,prosím? |
| * 2010-12-28 14:09:05 | Forrest Run | Ze 4., případně i ze 3. fotky zvrchu, mohu-li být tak smělý!      |
| + 2010-12-27 22:18:33 | Richard z Beskyd |  Jako vždy Jako vždy |
| - 2010-12-28 07:18:25 | Mahony | Pěkné výtvory zimy  |
| * 2010-12-28 18:44:49 | marek.11 |    |
| * 2010-12-27 19:52:59 | Kudláček |  Jak už jsem psal níže. Minulý týden tu bylo tak velké oteplení, že hodně sněhu odtálo. Místy se objevila holá místa, na kterých se objevila penízovka smrková a už i helmovka šiškomilná. Škoda, že přišlo opět velké ochlazení, protože je vše zmrzlé. Ze začátku jsem udělal pár fotografií přírody, ale pak už to ani nešlo ... Jak už jsem psal níže. Minulý týden tu bylo tak velké oteplení, že hodně sněhu odtálo. Místy se objevila holá místa, na kterých se objevila penízovka smrková a už i helmovka šiškomilná. Škoda, že přišlo opět velké ochlazení, protože je vše zmrzlé. Ze začátku jsem udělal pár fotografií přírody, ale pak už to ani nešlo ...  |
| + 2010-12-27 19:59:04 | Kudláček |  Další větvička Další větvička  |
| - 2010-12-27 20:00:17 | Kudláček |  Brrr to je zima Brrr to je zima  |
| * 2010-12-27 20:01:48 | Kudláček |  Zdraví Vás paní břízečka Zdraví Vás paní břízečka  |
| + 2010-12-27 20:03:14 | Kudláček |  Ještě jiný pohled Ještě jiný pohled  |
| - 2010-12-27 20:05:08 | javas | Krásný fotky Jiříku   |
| * 2010-12-27 20:07:55 | Kudláček | Ď  |
| * 2010-12-27 20:10:20 | kápo | co krásný-ledově krásný    |
| - 2010-12-27 21:42:46 | houbomil |    |
| - 2010-12-28 07:19:14 | Mahony | Nádhera, podařené  |
| - 2010-12-29 06:01:06 | fina | krásné děláš typ zimní pohlednice   |
| + 2010-12-27 20:56:35 | Forrest Run |    |
| - 2010-12-27 22:05:36 | zdeno | Tak...   |
| + 2010-12-27 22:17:57 | Richard z Beskyd | Fotky se stromy se ti povedli |
| - 2010-12-28 18:43:41 | marek.11 | pěkné záběry   |
| * 2010-12-29 20:35:46 | MILANOSS | Nádhera    |
| * 2010-12-27 18:57:21 | Forrest Run |  Honem sem přihodím něco zimou neprolezlýho, ať se tu skupinově při pohledu na monitor nerozklepeme jako "drahý psi"! Honem sem přihodím něco zimou neprolezlýho, ať se tu skupinově při pohledu na monitor nerozklepeme jako "drahý psi"!      Tohle je pořád ze stejnýho místa i dne...4.srpen u Chlumce n.C....fešnej dubáček ve stínu.. |
| + 2010-12-27 18:57:59 | Forrest Run |  A ve Slunci!:o) A ve Slunci!:o)     |
| + 2010-12-27 18:58:51 | Forrest Run |  Přívěskáčci rádi vápenec v substrátu! Přívěskáčci rádi vápenec v substrátu! |
| + 2010-12-27 18:59:33 | Forrest Run |  A na rozdíl od Rumcajzofskejch lokalit..... A na rozdíl od Rumcajzofskejch lokalit..... |
| + 2010-12-27 19:00:23 | Forrest Run |  Jsou tu jen vyjímečně červaví!:o) Jsou tu jen vyjímečně červaví!:o)     |
| - 2010-12-27 19:12:18 | kápo | to je pěkná provokace draku    |
| - 2010-12-28 07:19:58 | Mahony | Krásné nálezy  |
| * 2010-12-27 18:43:07 | houbomil |  Ahoj Lidičky Ahoj Lidičky Dnes přidám ještě několik fotek z pátku. Dnes přidám ještě několik fotek z pátku. |
| + 2010-12-27 18:44:15 | houbomil |  2. 2. |
| - 2010-12-27 18:44:57 | houbomil |  3. 3. |
| * 2010-12-27 18:45:37 | houbomil |  4. 4. |
| + 2010-12-27 18:46:15 | houbomil |  5. 5. |
| - 2010-12-27 18:47:11 | houbomil |  6. 6. |
| * 2010-12-27 18:47:53 | houbomil |  7. 7. |
| * 2010-12-27 18:49:39 | houbomil |  8. 8. |
| * 2010-12-27 18:54:47 | houbomil |  Tak se pro dněšek mějte hezky Tak se pro dněšek mějte hezky |
| * 2010-12-27 20:05:36 | kápo | č.7-outkovka hrbatá-nově zde v atlase |
| * 2010-12-28 10:40:44 | Rikki | Moc hezké, radost pohledět!!! |
| - 2010-12-27 19:05:25 | kápo | skutečně plodná štědrodenní procházka   |
| + 2010-12-27 18:51:16 | Forrest Run | Dobrá práce, George!:o)    Co si dáváš na vomrzliny?....Peruánskej balzám?    |
| - 2010-12-27 18:57:20 | houbomil | Jak už jsem psal včera-pršelo-teplo,jinak bych se do lesa nehnal Měj se Foreste ať se T daří Měj se Foreste ať se T daří |
| * 2010-12-27 20:09:01 | Kudláček | Jiří, u nás nebo u Vás je vše foceno ... |
| + 2010-12-27 21:41:48 | houbomil | Jiří-jak jsem včera psal Želez.hory jsou blízko Tvému bydlišti-takže skoro u Tebe Jinak příroda v okolí Hlinska-krása-houbařský ráj Jinak příroda v okolí Hlinska-krása-houbařský ráj Ať se Ti daří Ať se Ti daří A s těmi odtátými koly okolo smrků a malými penízovečkami máš pravdu-taky jsem to pozoroval.Měj se.J.V. A s těmi odtátými koly okolo smrků a malými penízovečkami máš pravdu-taky jsem to pozoroval.Měj se.J.V. |
| * 2010-12-27 20:55:49 | Forrest Run | Díky, díky, díky, Tobě taky, Draku!:o)    |
| + 2010-12-27 22:31:46 | Richard z Beskyd |  Good Good  |
| - 2010-12-28 07:20:45 | Mahony | Super  |
| * 2010-12-28 18:42:56 | marek.11 |    |
| + 2010-12-29 20:34:50 | MILANOSS |     |
| |< < > >| | ||